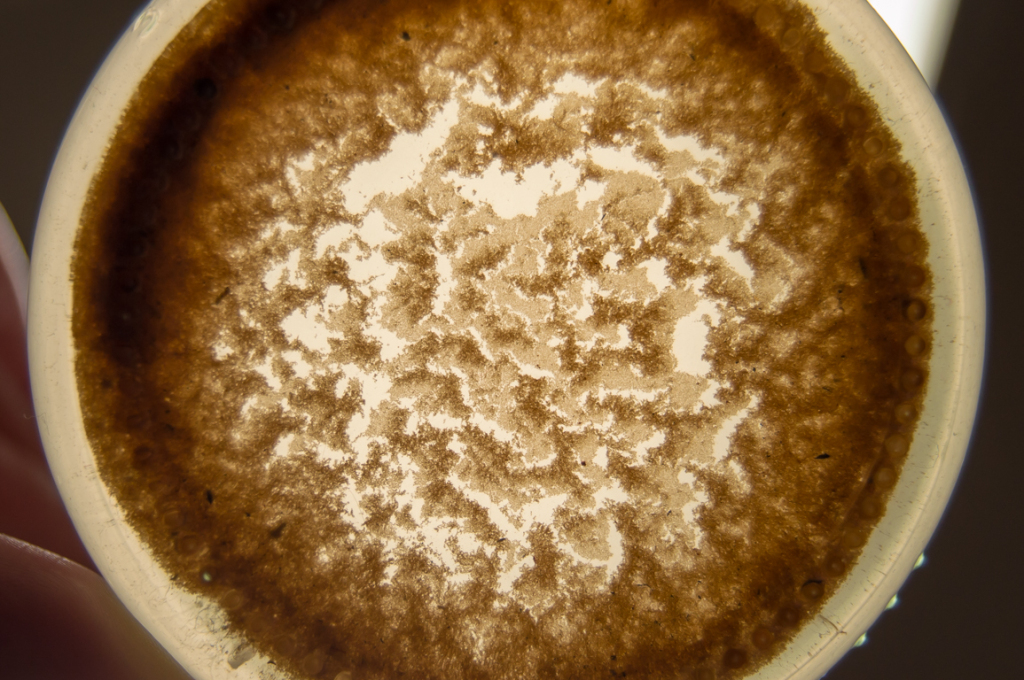
beillesztett kép

Meteorológiai társalgó
Hasznos linkek (és egy infó)
>> Sat24 műholdképek>> Sat24 Magyarország mozgó műholdkép
>> Magyarországi radarképek archívuma
>>Tippelek az előrejelzési verseny aktuális fordulójában!
>>Rádiószondás felszállások élő követése!
>>Észlelés (közeli villámlás, jégeső, viharos szél, villámárvíz, szupercella, tuba, porördög, tornádó, víztölcsér, viharkár) beküldése a szupercella.hu-nak!
----------
Képek beillesztése esetén kérjük azokat megvágni, reklámok, mobilok fejléce, stb. csak feleslegesen foglalja a helyet és áttekinthetetlenné teszi az oldalt - a vágatlan képek ezért törlésre kerülnek.
Fotózáskor kérjük a mobilt fektetve használni, egy keskeny de magas kép egyrészt szintén sok helyet foglal, másrészt a kép sem túl élvezetes.
Köszönjük az együttműködést és a megértést.
Ahogy elnézem, a Dunántúlra jobban bejön a vastag, homokos Cs, mint ahogy várható volt, bár este a műholdképek alapján már volt egy ilyen sejtésem.
Nem ennyi top 10 száraz hónapot 1612-1622 között hogy finoman fogalmazzak.
Egész pontosan a legcsapadékosabb 10 év 2005-2014. között volt hazánkban országos átlagban a mérések kezdete óta.
2017-2020-ig abban a 4 évben pedig beállt országos átlagban kevéssel 600 mm fölé mind a 4 év csapadékösszege.
Hasonló, mint 2006-2009-ig. Abban a 4 évben is hasonló volt az országos átlagú csapadékösszeg.
És abban a 4 évben is komoly aszályok voltak hazánkban.
Szóval nekem a 2017-2020. közötti 4 éves periódus teljes mértékben a 2006-2009-es 4 éves periódust idézte.
A 2021-es száraz év és eddig 2022. pedig a 2011-es és 2012-es igen száraz éveket idézi.
2017-2020-ig abban a 4 évben pedig beállt országos átlagban kevéssel 600 mm fölé mind a 4 év csapadékösszege.
Hasonló, mint 2006-2009-ig. Abban a 4 évben is hasonló volt az országos átlagú csapadékösszeg.
És abban a 4 évben is komoly aszályok voltak hazánkban.
Szóval nekem a 2017-2020. közötti 4 éves periódus teljes mértékben a 2006-2009-es 4 éves periódust idézte.
A 2021-es száraz év és eddig 2022. pedig a 2011-es és 2012-es igen száraz éveket idézi.
Közben ha jól tévedek, akkor az elmúlt évtized a mérések kezdete óta a legcsapadékosabb évtized volt.
De az átlagnál mindenképpen csapadékosabb volt.
Komoly kontraszt!
A csapadék rendkívül szélsőséges hektikusságát mutatja.
De az átlagnál mindenképpen csapadékosabb volt.
Komoly kontraszt!
A csapadék rendkívül szélsőséges hektikusságát mutatja.
Igen, és nem csak az ECMWF-en, hanem rendre a GFS-en is feltűnik március végére egy erősebb hidegöblítés.
Az, hogy milyen formában az még kérdéses. Valószínűbb a szárazabb verzió, de GFS pl. ma előhúzott egy mediterrán ciklonos verziót is a korábbi futásában.
Most nem tudom fejből pontosan melyik.
Az, hogy milyen formában az még kérdéses. Valószínűbb a szárazabb verzió, de GFS pl. ma előhúzott egy mediterrán ciklonos verziót is a korábbi futásában.
Most nem tudom fejből pontosan melyik.
ECM-et most tovább gondolva +2 nappal elég masszív hidegbetörés rajzolódhat a szemünk elé.. csak meglesz még egy havas medi is a szezonban.
De a hétvégi 15-20 fok legalább egyre stabilabb lábakon áll, hajrá tavasz!
Ez maga a dögunalom,és a tavasz porba fullad!
Az ember várja a változást,de már a tavalyi év is a pár milliméterek éve volt.Már az sincs mint a világ pár részén,hogy esős évszak száraz évszak,kiszámíthatatlan.Talán egyedül a májusunk maradt meg réginek.Sajnos már olyan vízhiányok vannak,hogy májusig nem igazán várhatunk.

Az ember várja a változást,de már a tavalyi év is a pár milliméterek éve volt.Már az sincs mint a világ pár részén,hogy esős évszak száraz évszak,kiszámíthatatlan.Talán egyedül a májusunk maradt meg réginek.Sajnos már olyan vízhiányok vannak,hogy májusig nem igazán várhatunk.
Ezekkel a statisztikai adatokkal csak az a baj, hogy 1622-ben vajon mit láttunk volna 1500-tól kezdődően feljegyzett adatokhoz képest? És mindez hogyan viszonyulna a mostaniakhoz?
Valahogy ott is elkezdődött anno....
A tetőablakokról és a kocsikról simán össze tudnék szedni egy homokozóvödörnyit én is.
A VW konkrétan leopárdmintás lett, elképesztően néz ki (és nem pozitív értelemben).
Asszonyé legalább eleve koszos volt, ott kevésbé látványosan szabályos.
Milyen jól tettem, hogy nem halgattam rá és nem vittem el mosatni a hétvégén
A tetőablakokról és a kocsikról simán össze tudnék szedni egy homokozóvödörnyit én is.
A VW konkrétan leopárdmintás lett, elképesztően néz ki (és nem pozitív értelemben).
Asszonyé legalább eleve koszos volt, ott kevésbé látványosan szabályos.
Milyen jól tettem, hogy nem halgattam rá és nem vittem el mosatni a hétvégén
Nálam már szépen ülepedik, amit gyűjtöttem, és elvileg ilyen szép narancsos színe lesz majd.

A szárazság témájához: kicsit több mint 10 évre visszatekintve:
1901 óta:
2011 november: legszárazabb
2012 március: legszárazabb
2012 augusztus: legszárazabb
2013 július: 3. legszárazabb
2013 december: 2.legszárazabb
2015 április: 5.legszárazabb
2015 június: 6.legszárazabb
2015 december: 3.legszárazabb
2016 december: 2.legszárazabb
2018 április: 6.legszárazabb
2019 március: 10.legszárazabb
2020 április: 4.leszárazabb
2020 november: 7.legszárazabb
2021 június: legszárazabb
és ugye a mostani jan/feb/márc.
Csupán véletlen? Hogyne.
1901 óta:
2011 november: legszárazabb
2012 március: legszárazabb
2012 augusztus: legszárazabb
2013 július: 3. legszárazabb
2013 december: 2.legszárazabb
2015 április: 5.legszárazabb
2015 június: 6.legszárazabb
2015 december: 3.legszárazabb
2016 december: 2.legszárazabb
2018 április: 6.legszárazabb
2019 március: 10.legszárazabb
2020 április: 4.leszárazabb
2020 november: 7.legszárazabb
2021 június: legszárazabb
és ugye a mostani jan/feb/márc.
Csupán véletlen? Hogyne.
Itt az aszfalt épphogy nedves lett, az autók sárosak, reggel a 6 fok meglepetés volt. Délutánra porzott a kert, úgyhogy öntöztem egy órát csőből. - és szereztem egy nylon csövet, klasszul le lehet ereszteni a kád vizét a kertbe rajta! A mai mosás (mosószer nélkül ment) már hasznosítva
Durva! Már ennek a 2013. márc. 15-i durvulatnak is 9 éve.
De fontos megjegyezni, hogy feltétlenül az időjárás volt főként a hibás, hanem az emberi nemtörődömség.
Én felelős állampolgárként viselkedtem, és nem mentem sehova, pedig lett volna, pl. egy fellépésre a szomszédos Pilisszántó községbe.
Tisztelet a kivételnek, akinek valóban útra kellett kelnie, de sok embernek nem is kellett volna, de azért mégis megindultak, mint Zrínyi a várból.
A felelőtlenség netovábbja pedig azt a történelmi káoszt szülte a közútjainkon, amiről mindenki tud, és már történelem.
De fontos megjegyezni, hogy feltétlenül az időjárás volt főként a hibás, hanem az emberi nemtörődömség.
Én felelős állampolgárként viselkedtem, és nem mentem sehova, pedig lett volna, pl. egy fellépésre a szomszédos Pilisszántó községbe.
Tisztelet a kivételnek, akinek valóban útra kellett kelnie, de sok embernek nem is kellett volna, de azért mégis megindultak, mint Zrínyi a várból.
A felelőtlenség netovábbja pedig azt a történelmi káoszt szülte a közútjainkon, amiről mindenki tud, és már történelem.
Viszont a keleti megyékben azóta esett szépen , van , ahol 5-10 mm között. A tavalyi júniust nem tudom beelőzöm-e (akkor 1,2 mm , most 1 mm a havi állás) ?
Persze, tiszta sor! Igaza van brekk20-nak, nem is állt szándékomban vitatni a kommentjét.
Jöjjön csak az igazán kellemes tavaszi meleg.
Csak annyi, hogy kár ezért a tovább fokozódó aszályért a továbbiakban.
A hideg idő mellett még tudtunk volna nyerni egy kis időt, gondolok itt a több mint fél napos fagyokra.
Mert hogy itt nem mostanság lesz kiadós esőzés, az egészen biztos.
Tudod, ha a fagyasztóból kiveszed az ételt, akkor időbe telik, míg kiolvad, aztán visszarakod újra a fagyasztóba, és újra megfagy.
Később romlik meg az étel.
Hasonló a mostani szituval. A hosszas éjjeli fagyok késleltették az aszály hirtelen még rosszabbra fordulását.
Jöjjön csak az igazán kellemes tavaszi meleg.
Csak annyi, hogy kár ezért a tovább fokozódó aszályért a továbbiakban.
A hideg idő mellett még tudtunk volna nyerni egy kis időt, gondolok itt a több mint fél napos fagyokra.
Mert hogy itt nem mostanság lesz kiadós esőzés, az egészen biztos.
Tudod, ha a fagyasztóból kiveszed az ételt, akkor időbe telik, míg kiolvad, aztán visszarakod újra a fagyasztóba, és újra megfagy.
Később romlik meg az étel.
Hasonló a mostani szituval. A hosszas éjjeli fagyok késleltették az aszály hirtelen még rosszabbra fordulását.
5 mm csak betalált a mérőbe mostanra.az eddigi éves csapadék jelentős része esett ma le. (10mm felett járunk már ezzel)
3 mm-re jók voltunk (2 mm éjszaka/hajnaltájt, meg egy jó kis homokos zápor délelőtt), Szolnok ennek a fele... Valahol hullott több? 24 órás csapitérképen talán Békésben.
Továbbra sem látni azt, hogy bárkaépítésbe kellene kezdenünk hamarosan.
Továbbra sem látni azt, hogy bárkaépítésbe kellene kezdenünk hamarosan.
Brutál adag por jött egyébként tényleg, főleg az antracid lemezen volt látványos, ahogy összefolyt egy helyre a poros víz, de gyakorlatilag minden tereptárgyon és autón meglátszik. Szűk 2 mm a pontos adat a hajnali záporokat illetően.
Ne beszélj már faszságot, mert megoldjuk a félelmeidet a sivatagos képeddel együtt
Reggel olyan hatalmas zápor volt, hogy még az aszfalt is vizes lett.
Na meg a kocsi egy homokozó.
Mekkora mázli, hogy az összes erdőben is van kiépített locsolórendszer, ugye vigyori?
A 16-18 fokoktól március végén már csak ne legyünk rosszul.
Mert a hideg száraz -5-10 fokos hajnalokkal valóban sokkal jobb lenne mindenkinek és megoldaná a problémát.
Köszi Donnie. Pontosan.
Mert a hideg száraz -5-10 fokos hajnalokkal valóban sokkal jobb lenne mindenkinek és megoldaná a problémát.
Köszi Donnie. Pontosan.
Az biztos, hogy a Mezőföld az utóbbi időben jó esélyekkel pályázhatna az első magyaroroszági sivatag címére.
Elképesztő mennyiség, 0.4 mm esett a reggeli "csapadékzónából". Ez egyben a márciusi csapadékösszeg is, az éves pedig már majdnem elérte a 12mm-t...
Még a zárt felhőzeten átszűrődő fény is sárga 
A homokozó holnap fog tetőzni, kíváncsi vagyok, felhők nélkül hogy fog kinézni.
Most így:
A homokozó holnap fog tetőzni, kíváncsi vagyok, felhők nélkül hogy fog kinézni.
Most így:

Én is egyetértek brekkel. Jöhetnének már a kellemesebb, 20 fok körüli hőmérsékletek. Se a reggeli fagy, se a napközbeni hűvös, télvégi idő már nem hiányzik. Legyen előbb meleg, aztán várhatóan a melegebb idő előbb-utóbb a csapadékot is meghozza!
Nem kívánságműsor 
Nomeg megkezdődött, legalábbis nálunk a mezőgazdasági tavasz. Most már hiába lenne még hidegebb, de szép sorban minden szétfagyna. A meleg így vagy úgy, de jönni fog.
Nomeg megkezdődött, legalábbis nálunk a mezőgazdasági tavasz. Most már hiába lenne még hidegebb, de szép sorban minden szétfagyna. A meleg így vagy úgy, de jönni fog.
A betonnak az kiváló 
Mondjuk nem szokásom brekk kommentjeit védeni, de szerintem ő nem a csapadékhiánynak örül, hanem attól elvonatkoztatva, csak a melegnek.
Aminek (a katasztrofális talajnedvesség-állapottól és a kertem miatt való aggodalomtól függetlenül) én is tudok örülni éppenséggel.
15 fokban a hordó csapvízzel feltöltése, meg a locsolás is kellemesebb, mint az 5-6ban
Mondjuk nem szokásom brekk kommentjeit védeni, de szerintem ő nem a csapadékhiánynak örül, hanem attól elvonatkoztatva, csak a melegnek.
Aminek (a katasztrofális talajnedvesség-állapottól és a kertem miatt való aggodalomtól függetlenül) én is tudok örülni éppenséggel.
15 fokban a hordó csapvízzel feltöltése, meg a locsolás is kellemesebb, mint az 5-6ban
Kurva jó mondhatom. 
Már csak a meleg hiányzik a szárazság mellé. Még jobban kiszárad minden.
Már csak a meleg hiányzik a szárazság mellé. Még jobban kiszárad minden.
Mérhető eső nem lett, csak autóüveg koszolásra lett elég.
Megnéztem a csapadékadatokat (tudom máshol még ennél is sokkal durvább):
2020 febr 17-ig: 67,9 mm (utána adathiány)
2020 márc. 16-ig: 78,5 mm
2021 márc. 16-ig: 47,7 mm
2022: 31,2 mm (utolsó mérhető febr. 21.)
A növények nagyon megindultak, hétvégére a mandula virágba borul, kajszi felkészül, fagyok szintén.
Megnéztem a csapadékadatokat (tudom máshol még ennél is sokkal durvább):
2020 febr 17-ig: 67,9 mm (utána adathiány)
2020 márc. 16-ig: 78,5 mm
2021 márc. 16-ig: 47,7 mm
2022: 31,2 mm (utolsó mérhető febr. 21.)
A növények nagyon megindultak, hétvégére a mandula virágba borul, kajszi felkészül, fagyok szintén.
0,4 mm, most szélvihar, hordja a port, szánalmas, ahogy az egész kilátások, számottevő csapadék a következő két hétben sem lesz....
Természetesen érdemi csapadék továbbra sem lesz, de legalább annyi látszik, h minden jel szerint a jövőhét elejétől fokozatosan és tartósan tavasziasra fordul a tavasz. Én ennek személy szerint nagyon, de nagyon örülök. Vagyis nem az egész márciust vágja gallyra a hideg. Ámen.
Hogy esni mikor fog legalább 5-10 mm csapadék..!? Passz.

A reggeli 1 mm után megemberelte magát az időjárás és már 6 mm-nél járunk, leesett az eddigi éves csapadék 2 óra alatt... Viszont én sarat nem észleltem az esőben.
Szia, itt nem váltott, szerintem már nem is fog, lassan vége a csapadéknak
Nem néztem még de kb. 5 mm körül lehet a mennyiség
Nálam meg az alatt, nem gondoltam, hogy még van lejjebb, …dehogynem gondoltam….
Megnézem, hol esett viszonylag sok, és odamegyünk kirándulni, a kisfiúnk pocsolyamániás.
Megnézem, hol esett viszonylag sok, és odamegyünk kirándulni, a kisfiúnk pocsolyamániás.
Sajnos a mai napot eddig lehúzhatjuk a wc-n..pedig nagyon bizakodtam. Viszont ez a kis eső jó,nagy koszt csinált..az autómosók like-olták.
Ferihegyen is 0,1 mm eddig, és itt is a mai hónap első nem fagyos napja. A március minimum-hőmérsékleteinek átlaga a tegnapi nappal bezárólag -6,9(!) °C volt, ami főként annank fényében érdekes, hogy a mögöttünk hagyott 3 téli hónap sorban -2,7; -4,7 és -1,6 °C-kal zárt ilyen téren.
Illetve az elmúlt napokban szépen belecsaptunk már az errefelé ilyenkor szokásos, nagy hőingásos időszakba, az utolsó 3 napon ez utóbbi érték rendre 20-22 °C között alakult.
Illetve az elmúlt napokban szépen belecsaptunk már az errefelé ilyenkor szokásos, nagy hőingásos időszakba, az utolsó 3 napon ez utóbbi érték rendre 20-22 °C között alakult.
